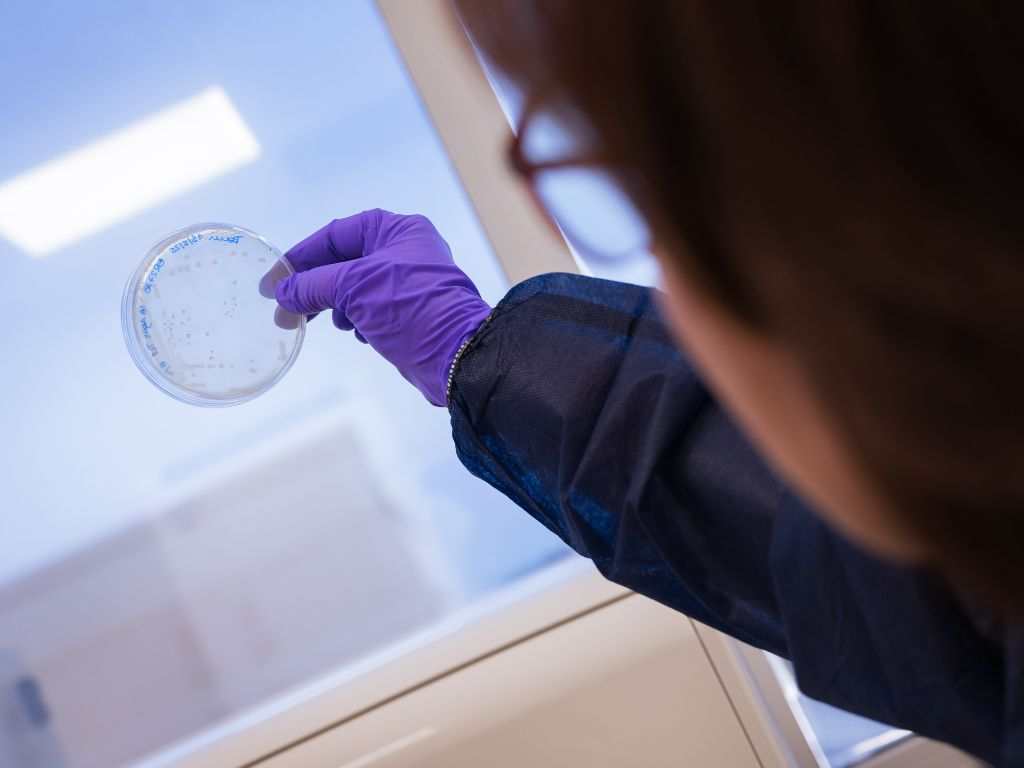
csic

El grupo de Nanobiotecnología para el Diagnóstico del Instituto de Química Avanzada de Cataluña (IQAC-CSIC) ha logrado un avance significativo en la lucha contra la bacteria Pseudomonas aeruginosa, calificada por la OMS como uno de los patógenos más peligrosos debido a su multirresistencia. El trabajo, publicado en la revista ACS Pharmacology and Translational Science, describe el desarrollo de un anticuerpo monoclonal (mAb122) diseñado específicamente para neutralizar la piocianina, una toxina que destruye células del sistema inmune y altera la respuesta inflamatoria del organismo.
A diferencia de los tratamientos convencionales, esta investigación sigue una estrategia de antivirulencia. Según explica la investigadora Llüisa Vilaplana, el enfoque no busca eliminar directamente al microorganismo, sino inhibir sus mecanismos de daño. Al no actuar sobre la viabilidad bacteriana, se reduce la presión selectiva y, por tanto, el riesgo de aparición de nuevas resistencias a los antibióticos. Las pruebas en macrófagos han demostrado que el anticuerpo mAb122 reduce el daño celular y aumenta notablemente la supervivencia de las células inmunitarias sin mostrar efectos tóxicos por sí solo.
La responsable del grupo, Pilar Marco, destaca que este tipo de terapias permiten desarmar a la bacteria, facilitando la acción natural del sistema inmunitario y permitiendo, en un futuro, el uso de dosis más bajas de antibióticos. Aunque la investigación se encuentra en fase temprana, los resultados abren la vía a estudios in vivo para evaluar la seguridad y la modulación de la respuesta inflamatoria en organismos completos, lo que podría transformar el tratamiento de infecciones graves en entornos hospitalarios.